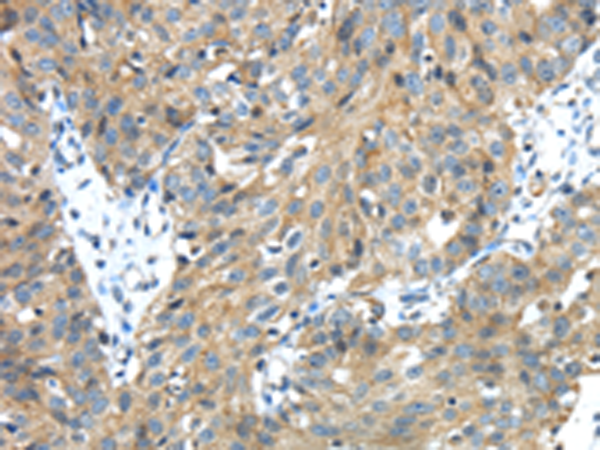

|
Background: |
This gene encodes a member of the type II transmembrane serine protease family. Transmembrane serine proteases are regulated by protease inhibitors and known to function in development, homeostasis, infection, and tumorigenesis. Multiple transcript variants encoding different isoforms have been found for this gene. |
|
Applications: |
ELISA, IHC |
|
Name of antibody: |
TMPRSS13 |
|
Immunogen: |
Fusion protein of human TMPRSS13 |
|
Full name: |
transmembrane protease, serine 13 |
|
Synonyms: |
MSP; MSPL; MSPS; TMPRSS11 |
|
SwissProt: |
Q9BYE2 |
|
ELISA Recommended dilution: |
2000-5000 |
|
IHC positive control: |
Human breast cancer |
|
IHC Recommend dilution: |
25-100 |
購物車
購物車 幫助
幫助
 021-54845833/15800441009
021-54845833/15800441009
